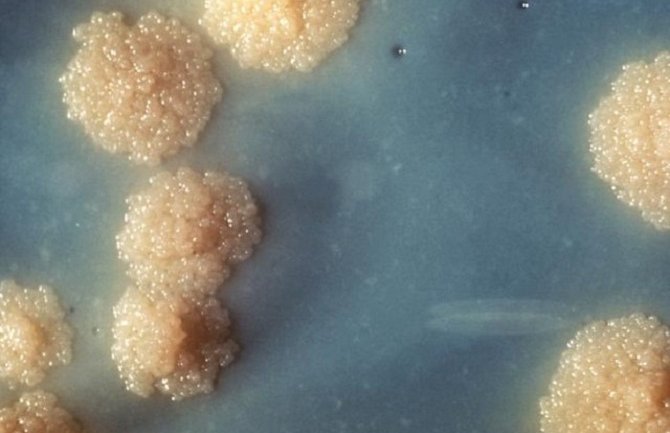
Otkriven antibiotik koji savladava otpor superbakterija

Naučnici sa Univerziteta Northeastern predvođeni Kimom Levisom su otkrili novi antibiotik "teixobactin" koji je kod miševa uspijevao izliječiti i vrlo jake infekcije ne nailazeći pritom na presnažan otpor bakterija, prenosi Anadlija.
U istraživanju se navodi da pomenuti aktibiotik omogućava uništenje zidova ćelija čime uništava bakterije.
Naučnici tvrde da bi antibiotik, koji se tek treba testirati na ljudima, u budućnosti mogao omogućiti liječenje mnogih infekcija.
Pomenuto istraživanje je objavljeno u naučnom magazinu "Nature".
Svjetska zdravstvena organizacija je prošle godine upozorila da porast otpora tijela na antibiotike predstavlja "globalnu prijetnju".
SZO navodi da zbog otpornosti antibioticima ljudi umiru od bezazlenih bolesti naglasivši da je potrebno razviti nove antibiotike.
Svake godine u svijetu zbog otpornosti prema antibioticima umre 700 hiljada osoba dok se strahuje da bi taj broj mogao porasti.

Komentari